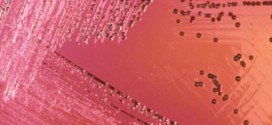
Health warning: 44 Salmonella Cases Linked to Frozen Poultry Products

Singer Avril Lavigne broke down in tears as she spoke to ABC News about having Lyme Disease. In the interview, an emotional Avril speaks about the doctors who didn’t take her health problems seriously initially.
Read More »World
Nicole Scherzinger : Singer sizzles in tiny bikini on sun-drenched holiday!
Nicole Scherzinger Is Celebrating Birthday In Bikini At Greece. The brunette beauty showed the Formula One ace exactly what he was missing as she flaunted her smokin’-hot-perfectly-chiseled bod in a cut-out bikini which clung to her every curve.
Read More »Amber Rose, Blac Chyna Kiss on the BET Awards Red Carpet ‘Video’
Sunday night Amber Rose and Blac Chyna attended the BET Awards as each other’s date, where they rocked the same sexy white suit to show their support for the Supreme Court ruling on marriage equality.
Read More »Kirk Pengilly: INXS rock star reveals shock at prostate cancer diagnosis
INXS founding member Kirk Pengilly has revealed he underwent surgery earlier this year to combat prostate cancer.
Read More »Finding Your Roots Suspended After Ben Affleck Had His Slave Ancestors Cut From Show (Video)
PBS has suspended genealogy show “Finding Your Roots” after an investigation determined that Ben Affleck was able to unduly influence decisions about the show’s content; specifically, when the program complied with Affleck’s request not to include details about his slave-owning great-great-great grandfather in an episode last October.
Read More »Ginger Zee Pregnant : ‘GMA’ Meteorologist Expecting First Child With Hubby Ben Aaron
Ginger Zee is pregnant. The “Good Morning America” meteorologist announced her pregnancy on the ABC breakfast show on Monday, June 29. “This is the most nervous I’ve been in a while,” she broke the news. “The forecast for delivery is in December.”
Read More »Sandra Bullock: Actress Looking Sleek at ‘Minions’ Premiere
Sandra Bullock hit the yellow carpet of “Minions” premiere at the Shrine Auditorium in Los Angeles on Saturday, June 27. The Oscar-winning actress went all out with her wardrobe as she wore flashy minion-inspired heels at the event.
Read More »Health warning: 44 Salmonella Cases Linked to Frozen Poultry Products
Amidst concerns of a salmonella outbreak, Health Canada has released a statement advising Canadians not to eat frozen raw breaded chicken products. The statement comes after the Public Health Agency tracked 44 cases of salmonella illnesses to four different provinces, including Ontario, which saw 28 cases.
Read More »Japan says goodbye to Tama, the cat stationmaster (Video)
A cat appointed stationmaster of a struggling Japanese railway has been mourned by railworkers at its funeral and elevated to the status of “honourable eternal stationmaster”.
Read More »Joni Mitchell cannot speak after suffering aneurysm, Ex David Crosby Says
Joni Mitchell suffered a brain aneurysm and is not speaking, David Crosby told Huffington Post Live on Friday.
Read More »Matthew James : Tunisia hero remains in hospital
Matthew James,Tunisia attack victim gives thumbs up in photo. A Welshman shot three times while protecting his fiancee from the gunman during the Tunisian terror attack is in stable condition in hospital back home. Mathew James, a father-of-two from Trehafod in Rhondda Cynon Taf, has been hailed as a hero after being shot in the shoulder, chest and hip after …
Read More » Canada Journal – News of the World Articles and videos to bring you the biggest Canadian news stories from across the country every day
Canada Journal – News of the World Articles and videos to bring you the biggest Canadian news stories from across the country every day